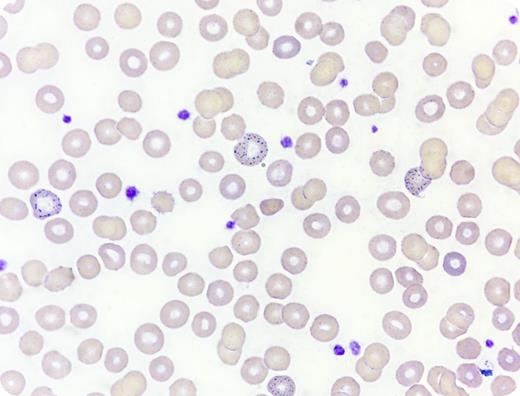
A 62-year-old woman presented with persistent periumbilical pain. She was found to have normochromic normocytic anemia (hemoglobin, 6.4 g/dL) and mild renal impairment (urea, 6.2 mmol/L; creatinine, 149 µmol/L). Gastrointestinal endoscopy was unrevealing. After admission, the patient developed generalized seizure. Blood film examination revealed frequent coarse basophilic stippling of red cells (original magnification ×100, Wright-Giemsa stain). Blood lead level was markedly raised (151 µg/dL; normal is <5 µg/dL). Dimercaptosuccinic acid chelation was commenced with subsequent improvement in hemoglobin level and renal function. Further history revealed that the patient consumed multiple herbal supplements for more than 1 year. A local toxicology reference laboratory detected extremely high lead levels in 1 of the herbal supplements (108 389 µg/mL). For reference, the US Food and Drug Administration adopts 0.5 µg/mL as the maximum level allowed for lead in products intended for use by children. / A lead level of 150 µg/dL is potentially lethal and could be associated with nephropathy and encephalopathy. In contrast to fine basophilic stippling in thalassemia, basophilic stippling is typically coarse in lead poisoning as a result of precipitation of RNA secondary to pyrimidine-5′-nucleotidase inhibition. Coarse basophilic stippling is also reported in pyrimidine-5′-nucleotidase deficiency and arsenic poisoning.

A 62-year-old woman presented with persistent periumbilical pain. She was found to have normochromic normocytic anemia (hemoglobin, 6.4 g/dL) and mild renal impairment (urea, 6.2 mmol/L; creatinine, 149 µmol/L). Gastrointestinal endoscopy was unrevealing. After admission, the patient developed generalized seizure. Blood film examination revealed frequent coarse basophilic stippling of red cells (original magnification ×100, Wright-Giemsa stain). Blood lead level was markedly raised (151 µg/dL; normal is <5 µg/dL). Dimercaptosuccinic acid chelation was commenced with subsequent improvement in hemoglobin level and renal function. Further history revealed that the patient consumed multiple herbal supplements for more than 1 year. A local toxicology reference laboratory detected extremely high lead levels in 1 of the herbal supplements (108 389 µg/mL). For reference, the US Food and Drug Administration adopts 0.5 µg/mL as the maximum level allowed for lead in products intended for use by children.
A lead level of 150 µg/dL is potentially lethal and could be associated with nephropathy and encephalopathy. In contrast to fine basophilic stippling in thalassemia, basophilic stippling is typically coarse in lead poisoning as a result of precipitation of RNA secondary to pyrimidine-5′-nucleotidase inhibition. Coarse basophilic stippling is also reported in pyrimidine-5′-nucleotidase deficiency and arsenic poisoning.
A 62-year-old woman presented with persistent periumbilical pain. She was found to have normochromic normocytic anemia (hemoglobin, 6.4 g/dL) and mild renal impairment (urea, 6.2 mmol/L; creatinine, 149 µmol/L). Gastrointestinal endoscopy was unrevealing. After admission, the patient developed generalized seizure. Blood film examination revealed frequent coarse basophilic stippling of red cells (original magnification ×100, Wright-Giemsa stain). Blood lead level was markedly raised (151 µg/dL; normal is <5 µg/dL). Dimercaptosuccinic acid chelation was commenced with subsequent improvement in hemoglobin level and renal function. Further history revealed that the patient consumed multiple herbal supplements for more than 1 year. A local toxicology reference laboratory detected extremely high lead levels in 1 of the herbal supplements (108 389 µg/mL). For reference, the US Food and Drug Administration adopts 0.5 µg/mL as the maximum level allowed for lead in products intended for use by children.
A lead level of 150 µg/dL is potentially lethal and could be associated with nephropathy and encephalopathy. In contrast to fine basophilic stippling in thalassemia, basophilic stippling is typically coarse in lead poisoning as a result of precipitation of RNA secondary to pyrimidine-5′-nucleotidase inhibition. Coarse basophilic stippling is also reported in pyrimidine-5′-nucleotidase deficiency and arsenic poisoning.
For additional images, visit the ASH IMAGE BANK, a reference and teaching tool that is continually updated with new atlas and case study images. For more information visit http://imagebank.hematology.org.